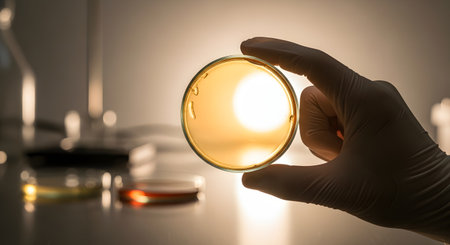
A scientist's gloved hand holds a petri dish containing a culture medium up to a light source for examination. The laboratory setting is sterile and focused, representing scientific research, microbiology, and analysis.の素材

素材 - A scientist's gloved hand holds a petri dish containing a culture medium up to a light source for examination. The laboratory setting is sterile and focused, representing scientific research, microbiology, and analysis.
作品情報
A scientist's gloved hand holds a petri dish containing a culture medium up to a light source for examination. The laboratory setting is sterile and focused, representing scientific research, microbiology, and analysis.
- ID:256303695
- 作品種別:
- 作者名:Mathew Aditya
類似作品
Surgeon showing...
Bioarcheology. ...
Woman doctor is...
scientist worki...
Asian male doct...
two scientists ...
lantern light a...
Scientist pipet...
Gloved Hand Hol...
Doctor in a whi...
doctor presses ...
Technician hold...
scientist worki...
scientist worki...
Laboratory work...
Blue latex glov...
Doctor female t...
Woman researche...
Woman in hazmat...
Doctor and Assi...
Researchers wor...
Doctors hand in...
Woman in blue m...
a doctor in a w...
Conceptual phot...
Close Up Of Fem...
Surgeon s glove...
Doctor's hand i...
Scientist hand ...
2 doses of Sars...
Taking a water ...
scientist or do...
Great concept o...
Researchers wor...
Scientist in pr...
The doctor puts...
Researchers wor...
Researchers wor...
Jars for hijama...
Oil spills conc...
BEIJING, CHINA ...
Doctor in a whi...
Santa Claus rea...
Peace sign with...
scientist worki...
Means of protec...
Man doctor or s...
Conceptual phot...
Closeup shot of...